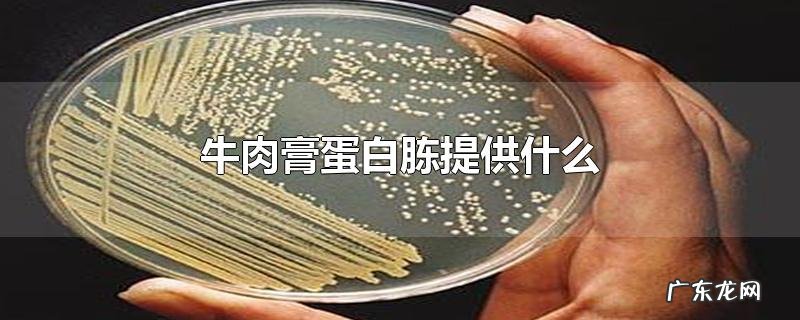
牛肉膏蛋白胨提供什么

牛肉膏蛋白胨主要提供碳源,氮源,磷酸盐,维生素和无机盐 。牛肉膏蛋白胨是一种琼脂培养基,因为价格相对便宜又容易制作,在微生物培养中有着广泛的应用 。
牛肉膏蛋白胨提供什么
文章插图
由于不同的微生物需要的营养不同,一种培养基不可能适合所有微生物,但牛肉膏蛋白胨培养基提供的营养是大部分微生物都需要的 。
牛肉膏蛋白胨培养基在制作与使用过程中需要注意规范使用,防止细菌污染,否则会使培养基失去营养 。
【牛肉膏蛋白胨提供什么】 在牛肉膏蛋白胨培养基制作过程中可以加入其他营养物质来制成不同的培养基,用来培养不同的微生物 。
(⊙o⊙)
特别声明:本站内容均来自网友提供或互联网,仅供参考,请勿用于商业和其他非法用途。如果侵犯了您的权益请与我们联系,我们将在24小时内删除。
